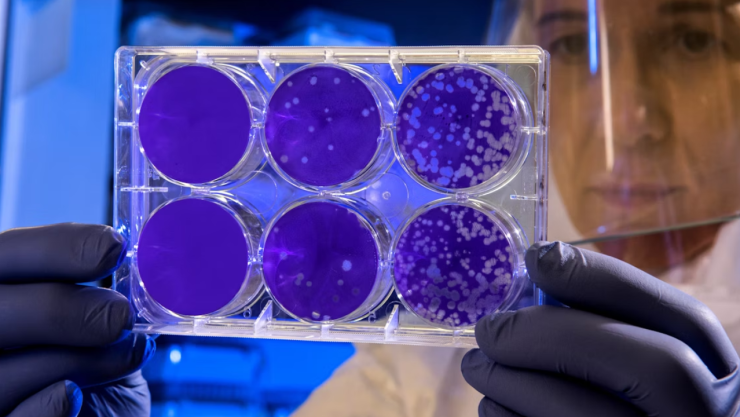
Alerta OMS por nuevo virus: Detectan una variante de COVID; la llaman “Frankenstein”

¡Nueva variante de COVID! La aparición de la subvariante XFG, apodada “Frankenstein” o Stratus, ha encendido una alarma global, especialmente tras su rápida expansión en Brasil, Europa y Sudamérica. Clasificada por la OMS como una variante bajo vigilancia, XFG surgió de la recombinación genética de las cepas LF.7 y LP.8.1.2, lo que le confiere mutaciones en la proteína Spike que potencian su transmisión, aunque no se ha demostrado que provoque síntomas más graves.
En Brasil,Brasil, informes del Instituto Oswaldo Cruz revelan que XFG ya representó hasta el 62 % de los casos en Río de Janeiro a inicios de julio, mientras que la OMS confirma su presencia en 38 países. Si bien todavía no se han notificado casos en Argentina, la variante se encuentra cerca y amerita vigilancia activa.
¿Qué es la subvariante XFG “Frankenstein”?
La subvariante XFG “Frankenstein” es un híbrido genético del SARS‑CoV‑2, resultado de la reunión de dos sublinajes ómicron, LF.7 y LP.8.1.2, lo que le dio un perfil de recombinante. Presenta varias mutaciones en la proteína Spike que podrían favorecer su evasión inmunológica, aunque la OMS la mantiene en vigilancia en lugar de declararla de preocupación.
¿Cuáles son los síntomas distintivos de la XFG?
La clínica de XFG es similar a la de otras variantes ómicron: fiebre, tos seca, dolor de garganta, fatiga, dolor de cabeza y malestar general. Sin embargo, uno de los signos más característicos es la ronquera o pérdida de voz, que puede ayudar a identificarla precozmente. También se han reportado síntomas gastrointestinales menos frecuentes como náusea, vómito o diarrea.
¿Qué tan contagiosa es la variante Frankenstein?
Los estudios y reportes de la OMS indican que XFG se está extendiendo con rapidez. En Brasil domina en zonas como Río de Janeiro, São Paulo, Ceará y Santa Catarina. En Europa, Inglaterra observó que su sublinaje XFG.3 ya representa hasta el 30–40 % de los casos, y globalmente constituye casi el 23 % de las secuenciaciones detectadas.
A pesar de su alta transmisibilidad, las vacunas actuales siguen protegiendo eficazmente frente a formas severas de COVID‑19 con XFG.
Cómo prevenir contagios de la subvariante XFG
- Vacunación actualizada: sigue siendo la medida clave para evitar hospitalizaciones.
- Uso de cubrebocas en espacios cerrados o concurridos.
- Ventilar ambientes regularmente para disminuir la carga viral.
- Aislamiento ante síntomas, especialmente si desarrollas ronquera, tos o fiebre.
- Evitar contacto con personas vulnerables, incluso si los síntomas son leves.
Sigue leyendo:
La última publicación de la actriz hallada sin vida en su casa; llevaba 9 meses desaparecida
En Tijuana mujer finge ser atropellada tras infidelidad
La ballena que cruzó por abajo la península de Baja California
De cazadores a mejores amigos del hombre: Así ha sido la evolución de los perros a lo largo del tiempo | VIDEO